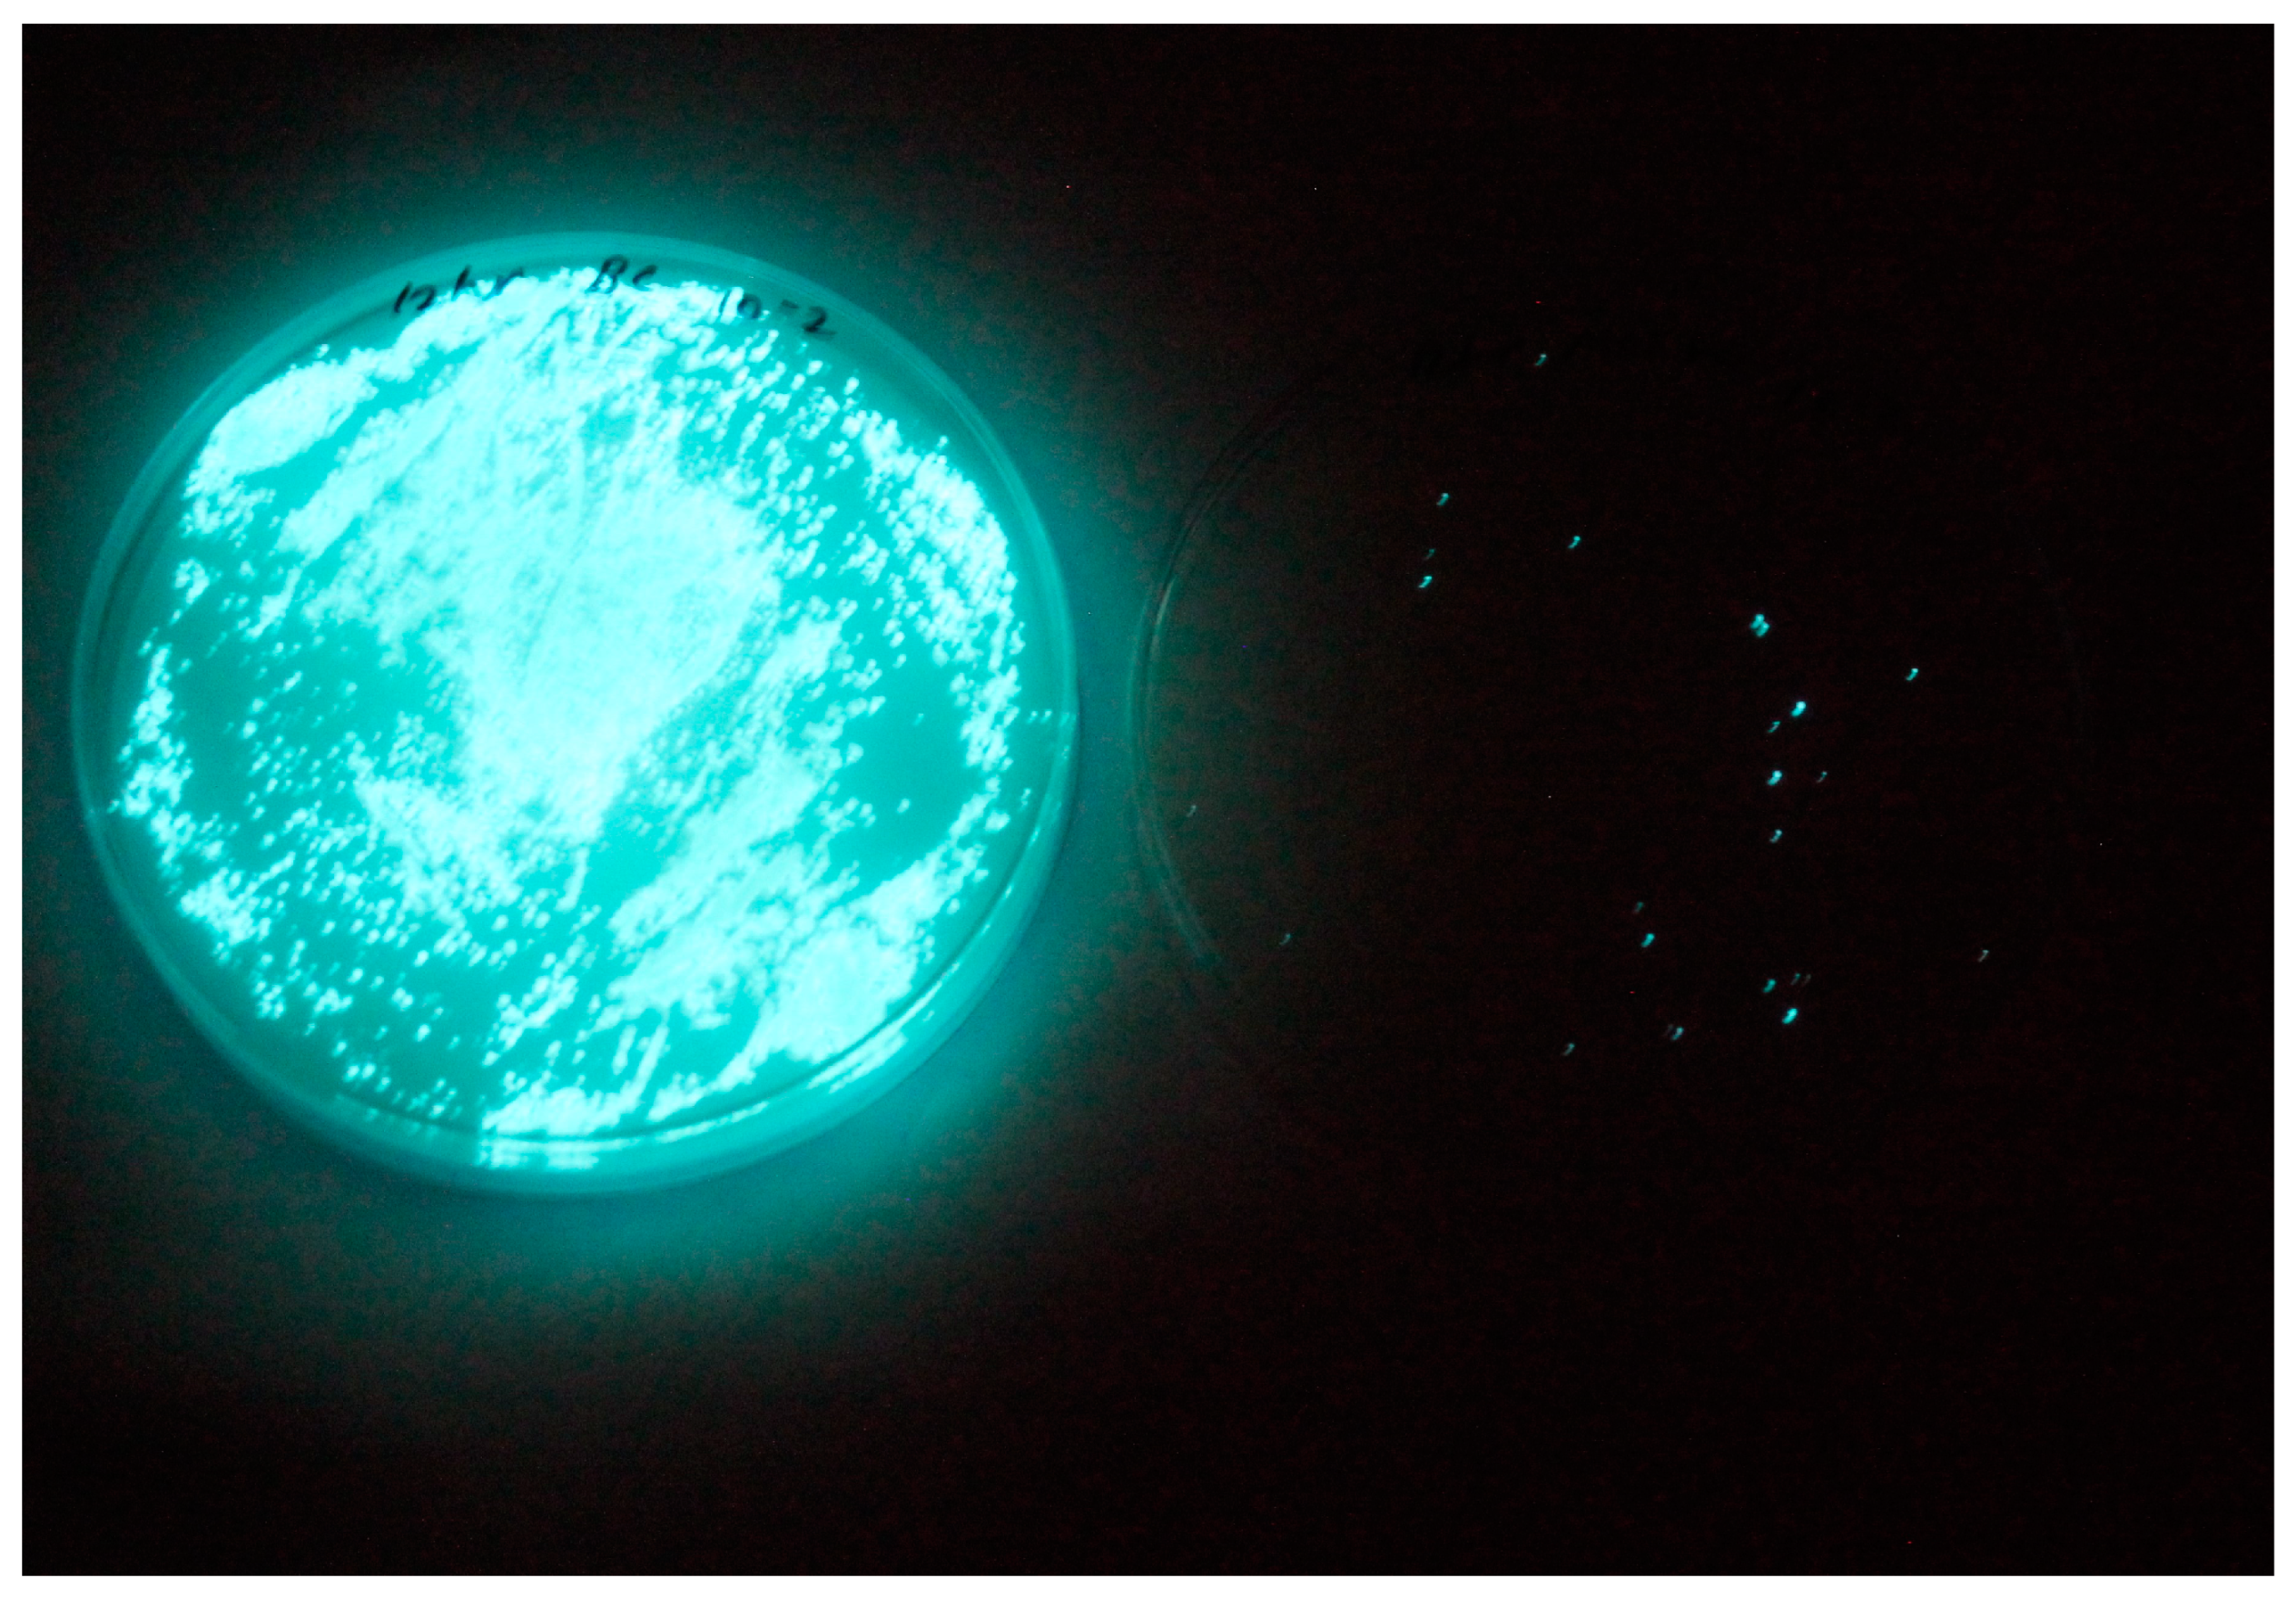

Genome Characterization and Infectivity Potential of Vibriophage-ϕLV6 with Lytic Activity against Luminescent Vibrios of Penaeus vannamei Shrimp Aquaculture
Abstract
1. Introduction
2. Material and Methods
2.1. Isolation of Luminescent V. harveyi Hosts
2.2. Isolation of Vibriophage
2.3. Purification and Precipitation of Vibriophage
2.4. TEM Morphology of Vibriophage-ϕLV6
2.5. Host Range Determination
2.6. DNA Extraction and Whole Genome Sequencing of Vibriophage-ϕLV6
2.7. Bioinformatic Analysis of Vibriophage-ϕLV6 Genome
2.8. In Vitro Determination of Optimum Multiplicity of Infection (MOI) for Determining Phage Infectivity Potential
2.9. In Vivo Challenge Studies to Assess the Ability of Vibriophage-ϕLV6 to Inhibit the Growth of Luminescent V. harveyi in P. vannamei Shrimp Post-Larvae Tanks
- Application of vibriophage-ϕLV6 at optimized MOI against a single luminescent V. harveyi host, i.e., LV6;
- Application of vibriophage-ϕLV6 at optimized MOIs against multiple (n = 6) luminescent Vibrio Hosts, i.e., LV6, LV36, LV38, LV40, LV44, and LV45.
2.9.1. Effectiveness of Vibriophage-ϕLV6 Application at Optimized MOI against a Single Luminescent V. harveyi Host
2.9.2. Effect of Vibriophage-ϕLV6 on the Growth of Multiple Luminescent Vibrio Hosts (n = 6)
2.10. Lytic Ability of Vibriophage-ϕLV6 under Different Salinity Conditions
2.11. Vibriophage-ϕLV6 Activity against Luminescent V. harveyi Host LV6 at Different Salt Gradients
2.12. Storage Stability of Vibriophage
2.13. Statistical Analysis
3. Results and Discussion
3.1. Isolation of Luminescent Vibrios
3.2. Isolation and Lytic Spectrum of Vibriophage
3.3. TEM Morphology of Vibriophage-ϕLV6
3.4. Vibriophage-ϕLV6 Genome Characterization and Phylogenetic Analysis
3.5. Intergenomic Comparison of Vibriophage-ϕLV6
3.5.1. Phylogenetic Analysis
3.5.2. Multiple Genome Alignments
3.5.3. Whole Genome Comparison
3.5.4. Comparison of the Genome of Vibriophage-ϕLV6 with the Genomes of Other Vibriophages Active against V. harveyi Clade
3.6. Vibriophage-ϕLV6 Proteome
3.7. Determination of Optimum Multiplicity of Infection
3.8. Challenge Studies to Test the In Vivo Lytic Ability of Vibriophage-ϕLV6
3.8.1. Effectiveness of Vibriophage-ϕLV6 Treatment at an Optimized MOI of 80 against a Single Luminescent V. harveyi-LV6
3.8.2. Effect of Vibriophage-ϕLV6 on Inhibiting the Growth of Multiple Luminescent Vibrio Hosts (n = 6)
3.9. Survivability of Vibriophage under Different Salinity Conditions
3.10. Stability Testing of Vibriophage-ϕLV6 Activity against Luminescent V. harveyi Host LV6 at Different Salt Gradients
3.11. Storage Stability of Vibriophage-ϕLV6
4. Discussion
5. Conclusions
Author Contributions
Funding
Institutional Review Board Statement
Informed Consent Statement
Data Availability Statement
Acknowledgments
Conflicts of Interest
References
- FAO. FAO Aquaculture News; December 2022, No. 66; FAO: Rome, Italy, 2022. [Google Scholar]
- Harris, L.J.; Owens, L. Production of exotoxins by two luminous Vibrio harveyi strains known to be primary pathogens of Penaeus monodon larvae. Dis. Aquat. Organ. 1999, 38, 11–22. [Google Scholar] [CrossRef]
- Ruangpan, L.; Danayadol, Y.; Direkbusarakom, S.; Siurairatana, S.; Flegel, T.W. Lethal toxicity of Vibrio harveyi to cultivated Penaeus monodon induced by a bacteriophage. Dis. Aquat. Organ. 1999, 35, 195–201. [Google Scholar] [CrossRef]
- Oakey, H.J.; Owens, L. A new bacteriophage, VHML, isolated from a toxin-producing strain of Vibrio harveyi in tropical Australia. J. Appl. Microbiol. 2000, 89, 702–709. [Google Scholar] [CrossRef] [PubMed]
- Selvin, J.; Huxley, A.J.; Lipton, A.P. Pathogenicity, antibiogram and biochemical characteristics of luminescent Vibrio harveyi associated with ’Black Shell Disease’ of Penaeus monodon. Fish Technol. 2005, 42, 191–196. [Google Scholar]
- Lavilla-Pitogo, C.R.; Baticados, M.C.L.; Cruz-Lacierda, E.R.; de la Pena, L.D. Occurrence of luminous bacterial disease of Penaeus monodon larvae in the Philippines. Aquaculture 1990, 91, 1–13. [Google Scholar] [CrossRef]
- Jiravanichpaisal, P.; Miyazaki, T.; Limsuwan, C. Histopathology, biochemistry, and pathogenicity of Vibrio harveyi Infecting black tiger prawn Penaeus monodon. J. Aquat. Anim. Health 1994, 6, 27–35. [Google Scholar] [CrossRef]
- Karunasagar, I.; Pai, R.; Malathi, G.R.; Karunasagar, I. Mass mortality of Penaeus monodon larvae due to antibiotic-resistant Vibrio harveyi infection. Aquaculture 1994, 128, 203–209. [Google Scholar] [CrossRef]
- Zhang, X.H.; He, X.; Austin, B. Vibrio harveyi: A serious pathogen of fish and invertebrates in mariculture. Mar. Life Sci. Technol. 2020, 2, 231–245. [Google Scholar] [CrossRef]
- Abraham, T.J.; Palaniappan, R. Distribution of luminous bacteria in semi-intensive penaeid shrimp hatcheries of Tamil Nadu, India. Aquaculture 2004, 232, 81–90. [Google Scholar] [CrossRef]
- Chrisolite, B.; Thiyagarajan, S.; Alavandi, S.V.; Abhilash, E.C.; Kalaimani, N.; Vijayan, K.K.; Santiago, T.C. Distribution of luminescent Vibrio harveyi and their bacteriophages in a commercial shrimp hatchery in South India. Aquaculture 2008, 275, 13–19. [Google Scholar] [CrossRef]
- Lulijwa, R.; Rupia, E.J.; Alfaro, A.C. Antibiotic use in aquaculture, policies and regulation, health and environmental risks: A review of the top 15 major producers. Rev. Aquac. 2020, 12, 640–663. [Google Scholar] [CrossRef]
- Rigos, G.; Kogiannou, D.; Padrós, F.; Cristòfol, C.; Florio, D.; Fioravanti, M.; Zarza, C. Best Therapeutic Practices for the Use of Antibacterial Agents in Finfish Aquaculture: A Particular View on European Seabass (Dicentrarchus labrax) and Gilthead Seabream (Sparus aurata) in Mediterranean Aquaculture. Rev. Aquac. 2021, 13, 1285–1323. [Google Scholar] [CrossRef]
- Vaiyapuri, M.; Pailla, S.; Badireddy, M.R.; Pillai, D.; Nagarajarao, R.C.; Mothadaka, M.P. Antimicrobial resistance in Vibrios of shrimp aquaculture: Incidence, identification schemes, drivers and mitigation measures. Aquac. Res. 2021, 52, 2923–2941. [Google Scholar] [CrossRef]
- Nurhafizah, W.W.I.; Lee, K.L.; Laith, A.A.R.; Nadirah, M.; Danish-Daniel, M.; Zainathan, S.C.; Najiah, M. Virulence properties and pathogenicity of multidrug-resistant Vibrio harveyi associated with luminescent vibriosis in Pacific white shrimp, Penaeus vannamei. J. Invetebr. Pathol. 2021, 186, 107594. [Google Scholar] [CrossRef]
- Rao, B.M.; Lalitha, K.V. Bacteriophages for aquaculture: Are they beneficial or inimical. Aquaculture 2015, 437, 146–154. [Google Scholar]
- Karunasagar, I.; Shivu, M.M.; Girisha, S.K.; Krohne, G.; Karunasagar, I. Biocontrol of pathogens in shrimp hatcheries using bacteriophages. Aquaculture 2007, 268, 288–292. [Google Scholar] [CrossRef]
- Letchumanan, V.; Chan, K.G.; Pusparajah, P.; Saokaew, S.; Duangjai, A.; Goh, B.H.; Mutalib, N.S.; Lee, L.H. Insights into Bacteriophage Application in Controlling Vibrio Species. Front. Microbiol. 2016, 7, 1114. [Google Scholar] [CrossRef] [PubMed]
- Schulz, P.; Pajdak-Czaus, J.; Siwicki, A.K. In Vivo Bacteriophages’ Application for the Prevention and Therapy of Aquaculture Animals–Chosen Aspects. Animals 2022, 12, 1233. [Google Scholar] [CrossRef]
- Ramos-Vivas, J.; Superio, J.; Galindo-Villegas, J.; Acosta, F. Phage Therapy as a Focused Management Strategy in Aquaculture. Int. J. Mol. Sci. 2021, 22, 10436. [Google Scholar] [CrossRef]
- Liang, X.; Wang, Y.; Hong, B.; Li, Y.; Ma, Y.; Wang, J. Isolation and Characterization of a Lytic Vibrio parahaemolyticus Phage vB_VpaP_GHSM17 from Sewage Samples. Viruses 2022, 14, 1601. [Google Scholar] [CrossRef]
- Ding, T.; Sun, H.; Pan, Q.; Zhao, F.; Zhang, Z.; Ren, H. Isolation and characterization of Vibrio parahaemolyticus bacteriophage vB_VpaS_PG07. Virus Res. 2020, 286, 198080. [Google Scholar] [CrossRef]
- Yang, M.; Liang, Y.; Huang, S.; Zhang, J.; Wang, J.; Chen, H.; Ye, Y.; Gao, X.; Wu, Q.; Tan, Z. Isolation and Characterization of the Novel Phages vB_VpS_BA3 and vB_VpS_CA8 for Lysing Vibrio parahaemolyticus. Front. Microbiol. 2020, 21, 259. [Google Scholar] [CrossRef] [PubMed]
- Richards, G.P.; Watson, M.A.; Madison, D.; Soffer, N.; Needleman, D.S.; Soroka, D.S.; Uknalis, J.; Baranzoni, G.M.; Church, K.M.; Polson, S.W.; et al. Bacteriophages against Vibrio coralliilyticus and Vibrio tubiashii: Isolation, Characterization, and Remediation of Larval Oyster Mortalities. Appl. Environ. Microbiol. 2021, 27, 8–21. [Google Scholar] [CrossRef] [PubMed]
- Silva, Y.J.; Costa, L.; Pereira, C.; Mateus, C.; Cunha, A.; Calado, R.; Gomes, N.C.; Pardo, M.A.; Hernandez, I.; Almeida, A. Phage therapy as an approach to prevent Vibrio anguillarum infections in fish larvae production. PLoS ONE 2014, 2, 114–197. [Google Scholar] [CrossRef]
- Le, T.S.; Southgate, P.C.; O’Connor, W.; Vu, S.V.; Kurtböke, D.İ. Application of bacteriophages to control Vibrio alginolyticus contamination in oyster (Saccostrea glomerata) larvae. Antibiotics 2020, 9, 415. [Google Scholar] [CrossRef]
- Kalatzis, P.G.; Bastías, R.; Kokkari, C.; Katharios, P. Isolation and characterization of two lytic bacteriophages, φSt2 and φGrn1; phage therapy application for biological control of Vibrio alginolyticus in aquaculture live feeds. PLoS ONE 2016, 7, e0151101. [Google Scholar] [CrossRef]
- Srisangthong, I.; Sangseedum, C.; Chaichanit, N.; Surachat, K.; Suanyuk, N.; Mittraparp-Arthorn, P. Characterization and Genome Analysis of Vibrio campbellii Lytic Bacteriophage OPA17. Microbiol. Spectr. 2023, 31, 0162322. [Google Scholar] [CrossRef] [PubMed]
- Vinod, M.G.; Shivu, M.M.; Umesha, K.R.; Rajeeva, B.C.; Krohne, G.; Karunasagar, I.; Karunasagar, I. Isolation of Vibrio harveyi bacteriophage with a potential for biocontrol of luminous vibriosis in hatchery environments. Aquaculture 2006, 225, 117–124. [Google Scholar] [CrossRef]
- Stalin, N.; Srinivasan, P. Efficacy of potential phage cocktails against Vibrio harveyi and closely related Vibrio species isolated from shrimp aquaculture environment in the south east coast of India. Vet. Microbiol. 2017, 207, 83–96. [Google Scholar] [CrossRef]
- Kang, S.; Zhang, L.; Liao, J.; Zhang, D.; Wu, S.; Zhang, X.; Qin, Q.; Wei, J. Isolation and Characterization of a Newly Discovered Phage, V-YDF132, for Lysing Vibrio harveyi. Viruses 2022, 14, 1802. [Google Scholar] [CrossRef]
- Wu, L.; Tian, Y.; Pang, M.; Yang, Z.; Bao, H.; Zhou, Y.; Sun, L.; Wang, R.; Zhang, H. A Novel Vibriophage VB_VhaS_PcB-1G Capable of Inhibiting Virulent Vibrio harveyi Pathogen. Aquaculture 2021, 542, 736854. [Google Scholar] [CrossRef]
- Quiroz-Guzmán, E.; Peña-Rodriguez, A.; Vázquez-Juárez, R.; Barajas-Sandoval, D.R.; Balcázar, J.L.; Martínez-Díaz, S.F. Bacteriophage cocktails as an environmentally-friendly approach to prevent Vibrio parahaemolyticus and Vibrio harveyi infections in brine shrimp (Artemia franciscana) production. Aquaculture 2018, 492, 273–279. [Google Scholar] [CrossRef]
- Pasharawipas, T.; Thaikua, S.; Sriurairatana, S.; Ruangpan, L.; Direkbusarakum, S.; Manopvisetcharean, J.; Flegel, T.W. Partial characterization of a novel bacteriophage of Vibrio harveyi isolated from shrimp culture ponds in Thailand. Virus Res. 2005, 114, 63–69. [Google Scholar] [CrossRef]
- Crothers-Stomps, C.; Høj, L.; Bourne, D.G.; Hall, M.R.; Owens, L. Isolation of lytic bacteriophage against Vibrio harveyi. J. Appl. Microbiol. 2010, 108, 1744–1750. [Google Scholar] [CrossRef]
- Surekhamol, I.S.; Deepa, G.D.; Pai, S.; Sreelakshmi, B.; Varghese, S.; Bright, I.S. Isolation and characterization of broad spectrum bacteriophages lytic to Vibrio harveyi from shrimp farms of Kerala, India. Lett. Appl. Microbiol. 2013, 58, 197–204. [Google Scholar] [CrossRef]
- Hyman, P. Phages for phage therapy: Isolation, characterization, and host range breadth. Pharmaceuticals 2019, 12, 35. [Google Scholar] [CrossRef] [PubMed]
- Misol, G.N., Jr.; Kokkari, C.; Katharios, P. Biological and genomic characterization of a novel jumbo bacteriophage, vB_VhaM_pir03 with broad host lytic activity against Vibrio harveyi. Pathogens 2020, 9, 1051. [Google Scholar] [CrossRef] [PubMed]
- Droubogiannis, S.; Raveearios, P. Genomic and Biological Profile of a Novel Bacteriophage, Vibrio phage Virtus, Which Improves Survival of Sparus aurata Larvae Challenged with Vibrio harveyi. Pathogens 2022, 11, 630. [Google Scholar] [CrossRef]
- Raveendran, K.; Vaiyapuri, M.; Benala, M.; Sivam, V.; Badireddy, M.R. Diverse infective and lytic machineries identified in genome analysis of tailed coliphages against broad spectrum multidrug-resistant Escherichia coli. Int. Microbiol. 2022. [Google Scholar] [CrossRef]
- Czyz, A.; Jasiecki, J.; Bogdan, A.; Szpilewska, H.; Wegrzyn, G. Genetically modified Vibrio harveyi strains as potential bioindicators of mutagenic pollution of marine environments. Appl. Environ. Microbiol. 2000, 66, 599–605. [Google Scholar] [CrossRef]
- Rao, B.M.; Surendran, P.K. Pathogenic vibrios in Penaeus monodon shrimp hatcheries and aquaculture farms. Fish Technol. 2013, 50, 161–167. [Google Scholar]
- Brenner, D.J.; Krieg, N.R.; Staley, J.T. Bergey’s Manual of Systematic Bacteriology, 2nd ed.; Part B, The Gamma Proteobacteria Order XI Vibrionales; Springer: New York, NY, USA, 2005; p. 491. [Google Scholar]
- Rao, B.M.; Surendran, P.K. Coliphage test: A quick and easy method to detect faecal pollution in water and fish. In Proceedings of the Symposium on Seafood Safety-Status and Strategies, Society of Fisheries Technologists, Cochin, India, 28–30 May 2003; pp. 556–561. [Google Scholar]
- Vaiyapuri, V.; Raveendran, K.; George, I.; Gundubilli, D.; Sivam, V.; Krishnan, S.G.; George, J.C.; Mothadaka, M.P.; Nagarajarao, R.C.; Badireddy, M.R. Comparison of single and multi-host enrichment approach for harnessing lytic phages against antimicrobial-resistant E. coli: Repurposing the enrichment step. Biologia 2021, 76, 1041–1052. [Google Scholar] [CrossRef]
- Karthika, R.; Iris, G.; Murugadas, V.; Jeswin, J.; Sherin, P.S.; Devi, S.; Visnuvinayagam, S.; Manikanta, B.; Prasad, M.M.; Rao, B.M. Characterization of tailed phages against E. coli using DNA restriction digestion analysis. Fish Technol. 2021, 58, 53–58. [Google Scholar]
- Jakočiūnė, D.; Moodley, A. A rapid bacteriophage DNA extraction method. Methods Protoc. 2018, 1, 27. [Google Scholar] [CrossRef] [PubMed]
- Al-Okaily, A.A. HGA: De novo genome assembly method for bacterial genomes using high coverage short sequencing reads. BMC Genom. 2016, 17, 193. [Google Scholar] [CrossRef] [PubMed]
- Besemer, J.; Borodovsky, M. GeneMark: Web software for gene finding in prokaryotes, eukaryotes and viruses. Nucleic Acids Res. 2005, 33, W451–W454. [Google Scholar] [CrossRef]
- Seemann, T. Prokka: Rapid prokaryotic genome annotation. Bioinformatics 2014, 30, 2068–2069. [Google Scholar] [CrossRef]
- Delcher, A.L.; Bratke, K.A.; Powers, E.C.; Salzberg, S.L. Identifying bacterial genes and endosymbiont DNA with Glimmer. Bioinformatics 2007, 23, 673–679. [Google Scholar] [CrossRef]
- Nishimura, Y.; Yoshida, T.; Kuronishi, M.; Uehara, H.; Ogata, H.; Goto, S. ViPTree: The viral proteomic tree server. Bioinformatics 2017, 33, 2379–2380. [Google Scholar] [CrossRef]
- Neve, H.; Zenz, K.I.; Desiere, F.; Koch, A.; Heller, K.J.; Brüssow, H. Comparison of the Lysogeny Modules from the Temperate Streptococcus thermophilus Bacteriophages TP-J34 and Sfi21: Implications for the Modular Theory of Phage Evolution. Virology 1998, 241, 61–72. [Google Scholar] [CrossRef]
- Iandolo, J.J.; Worrell, V.; Groicher, K.H.; Qian, Y.; Tian, R.; Kenton, S.; Dorman, A.; Ji, H.; Lin, S.; Loh, P.; et al. Comparative analysis of the genomes of the temperate bacteriophages φ11, φ12 and φ13 of Staphylococcus aureus 8325. Gene 2002, 289, 109–118. [Google Scholar] [CrossRef] [PubMed]
- Kumar, S.; Stecher, G.; Li, M.; Knyaz, C.; Tamura, K. MEGA X: Molecular evolutionary genetics analysis across computing platforms. Mol. Biol. Evol. 2018, 35, 1547. [Google Scholar] [CrossRef] [PubMed]
- Benala, M.; Vaiyapuri, M.; Visnuvinayagam, S.; George, J.C.; Raveendran, K.; George, I.; Mothadaka, M.P.; Badireddy, M.R. A revisited two-step microtiter plate assay: Optimization of in vitro multiplicity of infection (MOI) for Coliphage and Vibriophage. J. Virol. Methods 2021, 294, 114–177. [Google Scholar] [CrossRef] [PubMed]
- Joseph, T.C.; Rao, B.M.; Chandrarao, P.; Bibindas, K.S.; Lakshmi, T.R.; Joshy, C.G.; El Tholth, M.; Murray, F.C. Prophylactic health products use in Penaeus vannamei farms in Andhra Pradesh: Perception of shrimp farmers of north, central and south coastal regions. Indian J. Fish 2021, 68, 143–147. [Google Scholar] [CrossRef]
- Bate, S.T.; Clark, R.A. Stanford SC Using InVivoStat to perform the statistical analysis of experiments. J. Psychopharmacol. 2017, 31, 644–652. [Google Scholar] [CrossRef] [PubMed]
- Khemayan, K.; Prachumwat, A.; Sonthayanon, B.; Intaraprasong, A.; Sriurairatana, S.; Flegel, T.W. Complete Genome Sequence of Virulence-Enhancing Siphophage VHS1 from Vibrio harveyi. Appl. Environ. Microbiol. 2012, 78, 2790–2796. [Google Scholar] [CrossRef]
- Li, C.; Wang, Z.; Zhao, J.; Wang, L.; Xie, G.; Huang, J.; Zhang, Y. A Novel Vibriophage VB_VcaS_HC Containing Lysogeny-Related Gene Has Strong Lytic Ability against Pathogenic Bacteria. Virol. Sin. 2021, 36, 281–290. [Google Scholar] [CrossRef]
- Lawrence, J.G.; Hatfull, G.F.; Hendrix, R.W. Imbroglios of viral taxonomy: Genetic exchange and failings of phenetic approaches. J. Bacteriol. 2002, 184, 4891–4905. [Google Scholar] [CrossRef]
- Lima-Mendez, G.; Van Helden, J.; Toussaint, A.; Leplae, R. Reticulate representation of evolutionary and functional relationships between phage genomes. Mol. Biol. Evol. 2008, 25, 762–777. [Google Scholar] [CrossRef] [PubMed]
- Iranzo, J.; Krupovic, M.; Koonin, E.V. The double-stranded DNA virosphere as a modular hierarchical network of gene sharing. mBio 2016, 7, e00978-16. [Google Scholar] [CrossRef]
- Aiewsakun, P.; Adriaenssens, E.M.; Lavigne, R.; Kropinski, A.M.; Simmonds, P. Evaluation of the genomic diversity of viruses infecting bacteria, archaea and eukaryotes using a common bioinformatic platform: Steps towards a unified taxnomy. J. Gen. Virol. 2018, 99, 1331–1343. [Google Scholar] [CrossRef] [PubMed]
- Turner, D.; Shkoporov, A.N.; Lood, C.; Millard, A.D.; Dutilh, B.E.; Alfenas-Zerbini, P.; van Zyl, L.J.; Aziz, R.K.; Oksanen, H.M.; Poranen, M.M.; et al. Abolishment of morphology-based taxa and change to binomial species names: 2022 taxonomy update of the ICTV bacterial viruses subcommittee. Arch. Virol. 2023, 168, 74. [Google Scholar] [CrossRef] [PubMed]
- Baudoux, A.C.; Hendrix, R.W.; Lander, G.C.; Bailly, X.; Podell, S.; Paillard, C.; Johnson, J.E.; Potter, C.S.; Carragher, B.; Azam, F. Genomic and Functional Analysis of Vibrio Phage SIO-2 Reveals Novel Insights into Ecology and Evolution of Marine Siphoviruses. Environ. Microbiol. 2012, 14, 2071–2086. [Google Scholar] [CrossRef] [PubMed]
- Nurhafizah, W.W.I.; Alia, S.A.; Azna, N.S.; Lee, K.L.; Nadirah, M.; Laith, A.R.; Danish-Daniel, M.; Zainathan, S.C.; Shariff, M.M.D.; Mazlan, A.G.; et al. In-Vitro Characterization of Lytic Bacteriophage PhVh6 as Potential Biocontrol Agent against Pathogenic Vibrio harveyi. AACL Bioflux 2017, 10, 64–76. [Google Scholar]
- Lal, T.M.; Sano, M.; Ransangan, J. Isolation and Characterization of Large Marine Bacteriophage (Myoviridae), VhKM4 Infecting Vibrio harveyi. J. Aquat. Anim. Health 2017, 29, 26–30. [Google Scholar] [CrossRef]
- Shivu, M.M.; Rajeeva, B.C.; Girisha, S.K.; Karunasagar, I.; Krohne, G.; Karunasagar, I. Molecular Characterization of Vibrio harveyi Bacteriophages Isolated from Aquaculture Environments along the Coast of India. Environ. Microbiol. 2007, 9, 322–331. [Google Scholar] [CrossRef]
- Thiyagarajan, S.; Chrisolite, B.; Alavandi, S.V.; Poornima, M.; Kalaimani, N.; Santiago, T.C. Characterization of Four Lytic Transducing Bacteriophages of Luminescent Vibrio harveyi Isolated from Shrimp (Penaeus Monodon) Hatcheries. FEMS Microbiol. Lett. 2011, 325, 85–91. [Google Scholar] [CrossRef]
- Bailly-Bechet, M.; Vergassola, M.; Rocha, E. Causes for the intriguing presence of tRNAs in phages. Genome Res. 2007, 17, 1486–1495. [Google Scholar] [CrossRef]
- Tétart, F.; Desplats, C.; Kutateladze, M.; Monod, C.; Ackermann, H.W.; Krisch, H.M. Phylogeny of the major head and tail genes of the wide-ranging T4-type bacteriophages. J. Bacteriol. 2001, 183, 358–366. [Google Scholar] [CrossRef]
- Kalatzis, P.G.; Castillo, D.; Katharios, P.; Middelboe, M. Bacteriophage interactions with marine pathogenic vibrios: Implications for phage therapy. Antibiotics 2018, 7, 15. [Google Scholar] [CrossRef]
- Canchaya, C.; Fournous, G.; Chibani-Chennoufi, S.; Dillmann, M.L.; Brüssow, H. Phage as Agents of Lateral Gene Transfer. Curr. Opin. Microbiol. 2003, 6, 417–424. [Google Scholar] [CrossRef] [PubMed]
- Higuera, G.; Bastías, R.; Tsertsvadze, G.; Romero, J.; Espejo, R.T. Recently discovered Vibrio anguillarum phages can protect against experimentally induced vibriosis in Atlantic salmon, Salmo salar. Aquaculture 2013, 392, 128–133. [Google Scholar] [CrossRef]
- Jun, J.W.; Shin, T.H.; Kim, J.H.; Shin, S.P.; Han, J.E.; Heo, G.J.; De Zoysa, M.; Shin, G.W.; Chai, J.Y.; Park, S.C. Bacteriophage therapy of a Vibrio parahaemolyticus infection caused by a multiple-antibiotic–resistant O3: K6 pandemic clinical strain. J. Infect. Dis. 2014, 210, 72–78. [Google Scholar] [CrossRef] [PubMed]
- Zhang, L.; Song, X.; Hamel, J.F.; Mercier, A. Aquaculture, stock enhancement, and restocking. In Developments in Aquaculture and Fisheries Science; Elsevier: Amsterdam, The Netherlands, 2015; pp. 289–322. [Google Scholar]
- Li, Z.; Zhang, J.; Li, X.; Wang, X.; Cao, Z.; Wang, L.; Xu, Y. Efficiency of a bacteriophage in controlling vibrio infection in the juvenile sea cucumber Apostichopus japonicus. Aquaculture 2016, 451, 345–352. [Google Scholar] [CrossRef]
- Stalin, N.; Srinivasan, P. Characterization of Vibrio parahaemolyticus and its specific phage from shrimp pond in Palk Strait, South East coast of India. Biologicals 2016, 44, 526–533. [Google Scholar] [CrossRef]

| Sl.No | ORF/tRNA | Start Base | End Base | Nucleotide Length | Predicted Protein | Category |
|---|---|---|---|---|---|---|
| 1 | ORF 1 | 847 | 1851 | 1005 | Hypothetical Protein | Currently unknown |
| 2 | ORF 2 | 1864 | 2250 | 387 | Hypothetical Protein | Currently unknown |
| 3 | ORF 3 | 2247 | 6392 | 4146 | Tail tape measure protein | Structural |
| 4 | ORF 4 | 6405 | 6554 | 150 | Hypothetical Protein | Currently unknown |
| 5 | ORF 5 | 6605 | 7009 | 405 | Hypothetical Protein | Currently unknown |
| 6 | ORF 6 | 7086 | 7883 | 798 | Major tail protein | Structural |
| 7 | ORF 7 | 7941 | 8390 | 450 | Tail completion protein | Structural |
| 8 | ORF 8 | 8387 | 8857 | 471 | Neck protein | Structural |
| 9 | ORF 9 | 8857 | 9462 | 606 | Head completion adapter | Structural |
| 10 | ORF 10 | 9480 | 9794 | 315 | Hypothetical Protein | Currently unknown |
| 11 | ORF 11 | 9868 | 10,818 | 951 | Major capsid protein | Structural |
| 12 | ORF 12 | 10,886 | 12,040 | 1155 | Transport and Binding Protein | Additional function |
| 13 | ORF 13 | 12,041 | 12,667 | 627 | Hypothetical Protein | Currently unknown |
| 14 | ORF 14 | 12,789 | 13,115 | 327 | Hypothetical Protein | Currently unknown |
| 15 | ORF 15 | 13,129 | 15,057 | 1929 | Hypothetical Protein | Currently unknown |
| 16 | ORF 16 | 15,050 | 15,289 | 240 | Hypothetical Protein | Currently unknown |
| 17 | ORF 17 | 15,282 | 15,470 | 189 | Hypothetical Protein | Currently unknown |
| 18 | ORF 18 | 15,510 | 16,280 | 771 | Coil containing protein | Additional function |
| 19 | ORF 19 | 16,354 | 16,893 | 540 | Hypothetical Protein | Currently unknown |
| 20 | ORF 20 | 16,908 | 17,279 | 372 | Hypothetical Protein | Currently unknown |
| 21 | ORF 21 | 17,269 | 18,030 | 762 | Polyamine aminopropyl transferase | Additional function |
| 22 | ORF 22 | 18,032 | 18,226 | 195 | Hypothetical Protein | Currently unknown |
| 23 | ORF 23 | 18,333 | 18,881 | 549 | Hypothetical Protein | Currently unknown |
| 24 | ORF 24 | 18,881 | 19,198 | 318 | Hypothetical Protein | Currently unknown |
| 25 | ORF 25 | 19,274 | 19,651 | 378 | Hypothetical Protein | Currently unknown |
| 26 | ORF 26 | 19,645 | 20,028 | 384 | Hypothetical Protein | Currently unknown |
| 27 | ORF 27 | 20,218 | 22,155 | 1938 | Hypothetical Protein | Currently unknown |
| 28 | ORF 28 | 22,250 | 22,486 | 237 | Hypothetical Protein | Currently unknown |
| 29 | ORF 29 | 22,499 | 24,376 | 1878 | Hypothetical Protein | Currently unknown |
| 30 | ORF 30 | 24,471 | 24,782 | 312 | Hypothetical Protein | Currently unknown |
| 31 | ORF 31 | 24,802 | 25,536 | 735 | Hypothetical Protein | Currently unknown |
| 32 | ORF 32 | 25,588 | 26,301 | 714 | Hypothetical Protein | Currently unknown |
| 33 | ORF 33 | 26,306 | 26,560 | 255 | Hypothetical Protein | Currently unknown |
| 34 | ORF 34 | 26,563 | 26,922 | 360 | Hypothetical Protein | Currently unknown |
| 35 | ORF 35 | 26,935 | 27,432 | 498 | Hypothetical Protein | Currently unknown |
| 36 | ORF 36 | 27,435 | 27,779 | 345 | Hypothetical Protein | Currently unknown |
| 37 | ORF 37 | 27,763 | 28,176 | 414 | Hypothetical Protein | Currently unknown |
| 38 | ORF 38 | 28,323 | 28,727 | 405 | Hypothetical Protein | Currently unknown |
| 39 | ORF 39 | 28,724 | 29,125 | 402 | Hypothetical Protein | Currently unknown |
| 40 | ORF 40 | 29,118 | 29,561 | 444 | Hypothetical Protein | Currently unknown |
| 41 | ORF 41 | 29,569 | 29,982 | 414 | Hypothetical Protein | Currently unknown |
| 42 | ORF 42 | 30,435 | 31,250 | 816 | Hypothetical Protein | Currently unknown |
| 43 | ORF 43 | 31,411 | 31,752 | 342 | Hypothetical Protein | Currently unknown |
| 44 | ORF 44 | 31,798 | 32,142 | 345 | Hypothetical Protein | Currently unknown |
| 45 | ORF 45 | 32,300 | 32,740 | 441 | Hypothetical Protein | Currently unknown |
| 46 | ORF 46 | 32,740 | 32,985 | 246 | Hypothetical Protein | Currently unknown |
| 47 | t RNA | 33,833 | 33,916 | 84 | Lysine | Additional function |
| 48 | ORF 48 | 34,327 | 34,752 | 426 | Hypothetical Protein | Currently unknown |
| 49 | ORF 49 | 34,752 | 35,234 | 483 | Hypothetical Protein | Currently unknown |
| 50 | ORF 50 | 35,280 | 35,669 | 390 | Hypothetical Protein | Currently unknown |
| 51 | ORF 51 | 35,801 | 36,199 | 399 | Hypothetical Protein | Currently unknown |
| 52 | ORF 52 | 36,303 | 36,671 | 369 | Hypothetical Protein | Currently unknown |
| 53 | ORF 53 | 36,819 | 38,903 | 2085 | Hypothetical Protein | Currently unknown |
| 54 | ORF 54 | 38,906 | 39,238 | 333 | Hypothetical Protein | Currently unknown |
| 55 | ORF 55 | 39,228 | 40,010 | 783 | Hypothetical Protein | Currently unknown |
| 56 | ORF 56 | 40,110 | 40,238 | 129 | Hypothetical Protein | Currently unknown |
| 57 | ORF 57 | 40,818 | 41,078 | 261 | Hypothetical Protein | Currently unknown |
| 58 | ORF 58 | 41,161 | 41,376 | 216 | Hypothetical Protein | Currently unknown |
| 59 | ORF 59 | 41,366 | 41,824 | 459 | Hypothetical Protein | Currently unknown |
| 60 | ORF 60 | 41,821 | 42,075 | 255 | Hypothetical Protein | Currently unknown |
| 61 | ORF 61 | 42,075 | 42,263 | 189 | Hypothetical Protein | Currently unknown |
| 62 | ORF 62 | 42,244 | 42,627 | 384 | Putative DNA Polymerase | DNA metabolism |
| 63 | ORF 63 | 42,631 | 42,771 | 141 | Hypothetical Protein | Currently unknown |
| 64 | ORF 64 | 42,768 | 43,400 | 633 | Hypothetical Protein | Currently unknown |
| 65 | ORF 65 | 43,511 | 43,933 | 423 | Hypothetical Protein | Currently unknown |
| 66 | ORF 66 | 43,945 | 44,355 | 411 | TM Helix protein | Additional function |
| 67 | ORF 67 | 44,439 | 44,753 | 315 | Hypothetical Protein | Currently unknown |
| 68 | ORF 68 | 44,870 | 45,565 | 696 | DNA Methyltransferase | DNA metabolism |
| 69 | ORF 69 | 45,580 | 46,686 | 1107 | Par B Nuclease domain protein | Additional function |
| 70 | ORF 70 | 46,679 | 47,014 | 336 | MazG-like family protein | Additional function |
| 71 | ORF 71 | 47,030 | 48,874 | 1845 | Gene transfer agent portal protein | Additional function |
| 72 | ORF 72 | 48,938 | 51,307 | 2370 | DNA Polymerase | DNA metabolism |
| 73 | ORF 73 | 51,312 | 52,214 | 903 | Transporter protein | Additional function |
| 74 | ORF 74 | 52,205 | 53,263 | 1059 | Hypothetical Protein | Currently unknown |
| 75 | ORF 75 | 53,369 | 53,932 | 564 | Putative protein—Tyrosine phosphatase | Additional function |
| 76 | ORF 76 | 53,936 | 54,403 | 468 | Hypothetical Protein | Currently unknown |
| 77 | ORF 77 | 54,406 | 56,481 | 2076 | Pyruvate/phosphate dikinase | Additional function |
| 78 | ORF 78 | 56,547 | 56,936 | 390 | Coil containing protein | Additional function |
| 79 | ORF 79 | 56,946 | 57,509 | 564 | Hypothetical Protein | Currently unknown |
| 80 | ORF 80 | 57,499 | 57,738 | 240 | Hypothetical Protein | Currently unknown |
| 81 | ORF 81 | 57,873 | 58,118 | 246 | Hypothetical Protein | Currently unknown |
| 82 | ORF 82 | 58,132 | 60,006 | 1875 | Terminase large subunit | Packaging |
| 83 | ORF 83 | 60,003 | 60,830 | 828 | Coil containing protein | Additional function |
| 84 | ORF 84 | 60,845 | 61,204 | 360 | Hypothetical Protein | Currently unknown |
| 85 | ORF 85 | 61,268 | 62,251 | 984 | Hypothetical Protein | Currently unknown |
| 86 | ORF 86 | 62,460 | 63,014 | 555 | Cross over junction endodeoxyribonuclease | DNA metabolism |
| 87 | ORF 87 | 63,016 | 64,062 | 1047 | Rubredoxin-type fold protein | Additional function |
| 88 | ORF 88 | 64,052 | 64,462 | 411 | Hypothetical Protein | Currently unknown |
| 89 | ORF 89 | 64,416 | 65,510 | 1095 | RecA Protein | Additional function |
| 90 | ORF 90 | 65,543 | 65,902 | 360 | Hypothetical Protein | Currently unknown |
| 91 | ORF 91 | 65,904 | 66,305 | 402 | Putative DNA binding domain protein | Additional function |
| 92 | ORF 92 | 66,381 | 67,733 | 1353 | Putative DNA helicase | DNA metabolism |
| 93 | ORF 93 | 67,846 | 68,808 | 963 | Hypothetical Protein | Currently unknown |
| 94 | ORF 94 | 68,852 | 69,847 | 996 | DNA Primase | DNA metabolism |
| 95 | ORF 95 | 69,840 | 70,445 | 606 | Hypothetical Protein | Currently unknown |
| 96 | ORF 96 | 70,500 | 71,960 | 1461 | DNA B-like Helicase | DNA metabolism |
| 97 | ORF 97 | 71,969 | 72,550 | 582 | Hypothetical Protein | Currently unknown |
| 98 | ORF 98 | 72,560 | 74,215 | 1656 | Hypothetical Protein | Currently unknown |
| 99 | ORF 99 | 74,371 | 74,922 | 552 | Hypothetical Protein | Currently unknown |
| 100 | ORF 100 | 74,919 | 76,127 | 1209 | ATP-dependent zinc metalloprotease | Additional function |
| 101 | ORF 101 | 76,336 | 76,872 | 537 | TM Helix protein | Additional function |
| 102 | ORF 102 | 76,877 | 77,323 | 447 | Hypothetical Protein | Currently unknown |
| 103 | ORF 103 | 77,320 | 77,550 | 231 | Hypothetical Protein | Currently unknown |
| 104 | ORF 104 | 77,547 | 77,849 | 303 | Hypothetical Protein | Currently unknown |
| 105 | ORF 105 | 77,842 | 78,384 | 543 | Hypothetical Protein | Currently unknown |
| 106 | ORF 106 | 78,381 | 79,679 | 1299 | Hypothetical Protein | Currently unknown |
| 107 | ORF 107 | 79,689 | 79,862 | 174 | Hypothetical Protein | Currently unknown |
| Vibriophage-ϕLV6 | Siphophage-VHS1 | Vibriophage-vB_VhaM_pir03 | Vibriophage-VB_VhaS_PcB-1G | Vibriophage-VB_VcaS_HC | Vibriophage-Virtus | |
|---|---|---|---|---|---|---|
| Genome Size (bp) | 79,862 | 81,509 | 286,284 | 48,719 | 81,566 | 82,960 |
| G+C (%) | 48 | 46.87 | 43.6 | 43.06 | 47.6 | 47.42 |
| AnnotatedORFs | 138 | 125 | 137 | 80 | 121 | 127 |
| tRNAs | 1 | 0 | 0 | 0 | 0 | 0 |
| ARGs | Absent | Absent | Absent | Absent | Absent | Absent |
| Virulence genes | Absent | 1—Shrimp haemocyte agglutination | Absent | Absent | Absent | Absent |
| Integrase | Absent | Absent | Absent | Absent | Absent | Absent |
| Aquatic Animal Species | Shrimp (P. vannamei) | Shrimp (P. vannamei) | Brine shrimp (Artemia) | Fish (Zebrafish) | - | Fish (Gilt Head Sea Bream) |
| Country | India | Thailand | Greece | China | China | Greece |
| Ref. | (This study) | [59] | [38] | [32] | [60] | [39] |
| Period of Storage at 4 °C (Months) | Vibriophage Count (Log Pfu mL−1) |
|---|---|
| 0 | 10.5 |
| 1 | 10.5 |
| 4 | 10.7 |
| 9 | 10.4 |
| 12 | 9.7 |
Disclaimer/Publisher’s Note: The statements, opinions and data contained in all publications are solely those of the individual author(s) and contributor(s) and not of MDPI and/or the editor(s). MDPI and/or the editor(s) disclaim responsibility for any injury to people or property resulting from any ideas, methods, instructions or products referred to in the content. |
© 2023 by the authors. Licensee MDPI, Basel, Switzerland. This article is an open access article distributed under the terms and conditions of the Creative Commons Attribution (CC BY) license (https://creativecommons.org/licenses/by/4.0/).
Share and Cite
Benala, M.; Vaiyapuri, M.; Sivam, V.; Raveendran, K.; Mothadaka, M.P.; Badireddy, M.R. Genome Characterization and Infectivity Potential of Vibriophage-ϕLV6 with Lytic Activity against Luminescent Vibrios of Penaeus vannamei Shrimp Aquaculture. Viruses 2023, 15, 868. https://doi.org/10.3390/v15040868
Benala M, Vaiyapuri M, Sivam V, Raveendran K, Mothadaka MP, Badireddy MR. Genome Characterization and Infectivity Potential of Vibriophage-ϕLV6 with Lytic Activity against Luminescent Vibrios of Penaeus vannamei Shrimp Aquaculture. Viruses. 2023; 15(4):868. https://doi.org/10.3390/v15040868
Chicago/Turabian StyleBenala, Manikantha, Murugadas Vaiyapuri, Visnuvinayagam Sivam, Karthika Raveendran, Mukteswar Prasad Mothadaka, and Madhusudana Rao Badireddy. 2023. "Genome Characterization and Infectivity Potential of Vibriophage-ϕLV6 with Lytic Activity against Luminescent Vibrios of Penaeus vannamei Shrimp Aquaculture" Viruses 15, no. 4: 868. https://doi.org/10.3390/v15040868
APA StyleBenala, M., Vaiyapuri, M., Sivam, V., Raveendran, K., Mothadaka, M. P., & Badireddy, M. R. (2023). Genome Characterization and Infectivity Potential of Vibriophage-ϕLV6 with Lytic Activity against Luminescent Vibrios of Penaeus vannamei Shrimp Aquaculture. Viruses, 15(4), 868. https://doi.org/10.3390/v15040868

